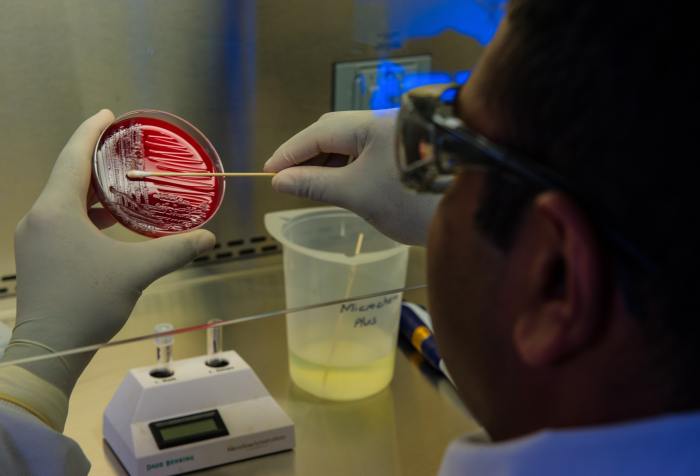

Der er ingen tegn på selvreplikerende RNA-molekyler, og det er svært at forestille sig overgangen til et RNA-protein-system, lyder kritikken i det ansete fagblad Trends in Ecology & Evolution.
I går begyndte jeg at gennemgå en artikel fra Phys.org om den nyeste forskning i livets oprindelse og resultaterne af et eksperiment på Cambridge fra nogle af verdens førende forskere … Continue Reading Den seneste forskning i livets oprindelse, 2
Jeg har på det seneste skrevet om forskningen i livets oprindelse. Jeg kom i den forbindelse med nogle kritiske påstande såsom et citat fra Cambridgeprofessor Dr. Simon Conway Morris, … Continue Reading Den seneste forskning i livets oprindelse
En af de vrangforestillinger, som evolutionstvivlere er oppe imod, er den udbredte tro, at Darwins teori mere eller mindre er bevist – at ”evolution is a fact”, som Richard Dawkins … Continue Reading Etableret videnskab
Selv om livets oprindelse fortsat er et mysterium, tilslutter så godt som alle videnskabsfolk inden for området sig generelt ideen om, at liv kan reduceres til kemi. George M. Whitesides … Continue Reading Livets oprindelse: informationsudfordringen
En venlig læser af http://www.intelligentdesign.dk har sendt følgende spørgsmål: ”Der er en ting jeg undrer mig over. Og det er at tilhængerne af Intelligent Design ikke tager det fulde skridt og … Continue Reading Hvorfor ikke deklarere en ny religion?
I serien om glemte, oversete og undertrykte arkæologiske fund, der tyder på eksistensen af mennesker (Homo sapiens) i tider, hvor der ifølge gængse nutidige opfattelser om menneskets oprindelse ikke kan have … Continue Reading Flere glemte 1800-tals fund

Intelligent design er et alternativt perspektiv, der giver anledning til andre spørgsmål end det naturalistiske perspektiv.
Selv om linjen her på Intelligent Design DK er at forholde sig til det rent videnskabelige og gå uden om f.eks. politiske holdninger, vil jeg alligevel tillade mig at … Continue Reading Darwinisme og racisme
Intelligent design hypotesen er ilde set i den akademiske verden. IDs modstandere prøver ihærdigt at overbevise den brede befolkning om, at når ID ikke får foden indenfor på universiteterne, er … Continue Reading Det forestående paradigmeskifte
Jeg har på det seneste skrevet frem og tilbage om historien i forskningen i livets oprindelse (se del 1, del 2, del 3 og del 4). Sidste afsnit handlede om … Continue Reading Hvis grise kunne flyve
“Hvem gider læse lange artikler?” bliver flere af mine unge bekendte ved med at fortælle mig. “Det hele skal gå hurtigt, der skal video og lyd på, og det må … Continue Reading Haeckels bedrag afsløret endnu engang
Som Krauze nævnte det i lørdags (og også her) og Karsten Pultz også har været inde på det nogle gange (se her), støder man somme tider på et argument om … Continue Reading Uperfekt design – et argument imod intelligent design?